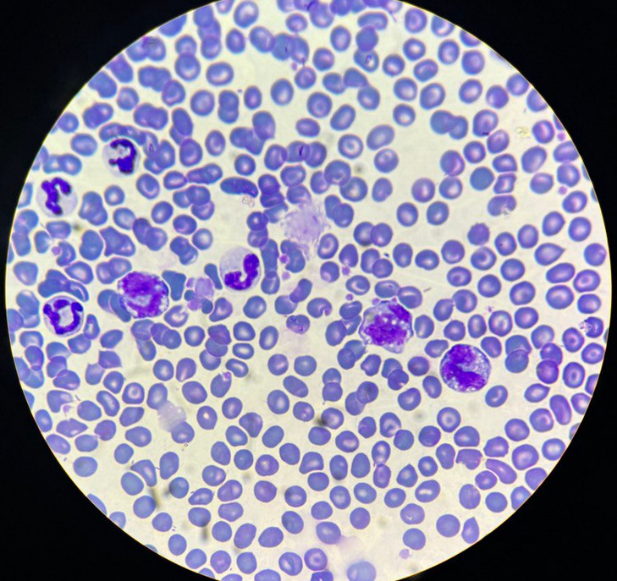

Олександр Гаєвський – майбутні ветеринарні хірурги обирають НУБіП України
Випускник відокремленого структурного підрозділу «Немішаївський фаховий коледж Національного університету біоресурсів і природокористування України» Олександр Гаєвський мріє стати ветеринарним хірургом.

Напрям хірургії Олександр уподобав, коли слухав на заняттях свого викладача доктора філософії Олександра Шупіка, спостерігав за роботою практикуючого лікаря Михайла Фещака, тож перші фахові зерна знань були влучно «засіяні на благодатний ґрунт» свідомості Олександра.
Випускники факультету ветеринарної медицини НУБІП України отримують диплом магістра за спеціальністю «Лікар ветеринарної медицини», що дає багато можливостей спрямувати свою роботу у різних напрямах ветеринарії – терапії, хірургії, ортопедії, лабораторній та візуальній діагностиці, інтенсивній терапії, анестезіології, тропічній ветеринарії та ін. Поряд з базовими дисциплінами, які формують програму підготовки ветеринарного лікаря в НУБІП України є велика кількість вибіркових дисциплін, які додатково надають студентам сучасну теоретичну інформацію і практичний досвід. Таким чином, студенти набувають під час навчання додаткових знань і навичок за обраною спеціалізацією, що підвищує їх кваліфікацію і є запорукою успішної професійної діяльності в умовах надзвичайно високої конкуренції.
Матеріально-технічна база факультету ветеринарної медицини НУБіП України є основою для забезпечення викладання дисциплін на високому навчально-методичному рівні. На Дні відкритих дверей в НУБіП України Олександр ознайомився з сучасними навчальними та науковими лабораторіями, які оснащені високотехнологічним обладнанням, науково-педагогічним персоналом факультету ветеринарної медицини та зрозумів, що зробив правильний вибір університету і майбутньої спеціальності.
Олександру особливо сподобалися навчальні лабораторії фізіології тварин, де наочно було продемонстровано дослідження крові, сечі тварин, апарату дихання, і абітурієнти власноруч змогли торкнутися майбутніх занять; навчально-наукова лабораторія репродуктології на кафедрі dетеринарної репродуктології НУБіП України, де можна досліджувати і оцінювати якість сперми плідників; клініка «Ветмедсервіс», де є найсучасніше обладнання для повної діагностики і лікування тварин; навчальні лабораторії та операційні кафедри ветеринарної хірургії ім. акад. І.О. Поваженка.

Отже, абітурієнти 2024 року вступу зробили свій вибір разом з факультетом ветеринарної медицини НУБіП України!
Успіхів у навчанні!
Доктор ветеринарних наук, професор
Лариса Кладницька